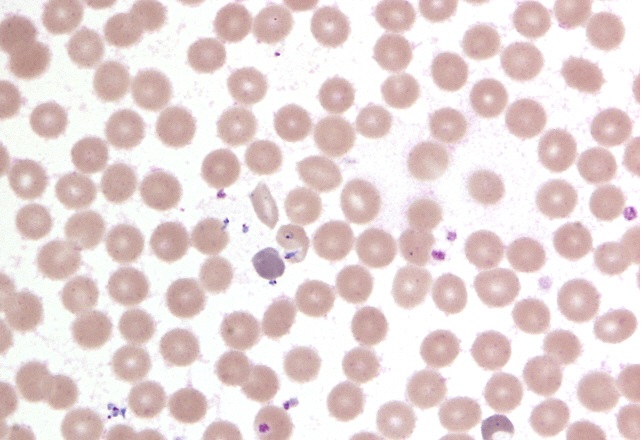
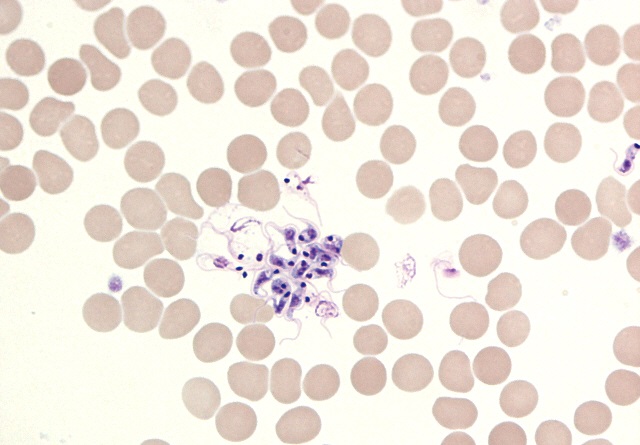
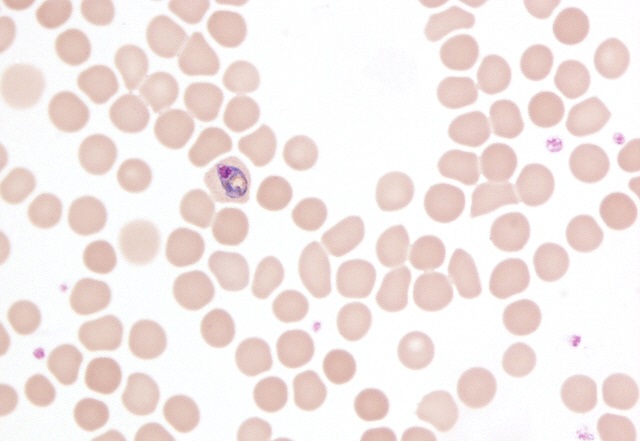

About This Project
Parasitic infections have been previously associated with prostate and bladder cancer. Our preliminary results suggest that parasitic infections might play a role in prostate cancer. We would like to study 12 prostate cancer samples using Next Generation DNA sequencing to detect and identify new or unexpected infections. If new parasitic infections are discovered prostate cancer might be preventable by vaccines or controlled by antiparasitics.Ask the Scientists
Join The DiscussionWhat is the context of this research?
Dr. Fry’s practice has been managing of Chronic
Fatigue Syndrome (CFS) for many years. During that time he has documented 5 male patients with CFS that rapidly developed prostate cancer. Our previous work has identified a variety of protoza in patients with CFS. Some of these organisms are related to Perkinsus marinus, that produces tumors in oysters similar to prostatic carcinoma. As our genomic mapping research progresses we suspect these organisms may have a role in the initiation, formation, or progression of prostate cancer. Schistosoma, another parasite, has been implicated in bladder cancer and more recently in adenocarcinoma of the prostate. If the samples are shown to harbor detectable levels previously unrecognized organisms then additional investigation is warranted.
What is the significance of this project?
We have hypothesized that human prostatic carcinoma could be triggered by an unrecognized protozoal infection. If supported by a study such as the one proposed here then it may yield new methods to control this disease prevalence through transmission vector and reservoir elimination, and potential vaccine development. Additionally, identifying these infectious risk factors may aid in the development of superior prostate cancer treatment medications. The concept of an infectious agent in prostate cancer is not necessarily novel; however, if conclusively identified, it may have significant consequences for the future of this disease. Control of the parasite Schistosomia in Egypt has been successful in reducing bladder cancer rates. Could similar successes be possible with prostate cancer?
What are the goals of the project?
1. Patients independently undergoing prostate surgery will have the prostates removed and sent to the hospital pathology laboratory. Acceptable cancer samples are categorized and de-identified by the hospital pathologist and sent to the analysis laboratory.
2. Total genomic DNA is extracted from the prostate cancer samples including human, bacterial, and protozal DNA.
3. Survey the presence of bacterial and protozoan DNA signatures from the samples by Next Generation DNA Sequencing.
4. Compile the findings via metagenomic analysis and determine common organism risk factors and relative abundances.
5. If organisms are discovered determine the true abundances of the organisms/factors via follow up testing.
Budget
This project is in-between a large agency funded medical project and the smaller directly funded pilot study. The SWCCD is a 501(c)(3) nonprofit and, if funded, contributors will receive letters for tax deduction purposes. Experiment.com is uniquely positioned to support a mid-range study. The main expenditure for the project is the Next Generation DNA sequencing reagents and materials. The rights of the enrolled participants undergoing prostate cancer surgery are protected by a Human Subjects Committee or Institutional Review Board. The hospitals performing the prostate removal also apply fees for appropriate handling, transport, and collection of acceptable samples. We intend to publish this study in an open access format and anticipate ancillary publication fees. Another significant source of funds will be required for the sequencing facility as logistical support for data collection and analysis have an associated cost. Lastly, we have included the Experiment.com Fees for clarity.
Meet the Team
Team Bio
In addition to being the Founder of the Southwest Center for Chronic Disease, Stephen E. Fry, M.S., M.D., is an active General Practitioner in Scottsdale. Dr. Fry first became interested in autoimmune and chronic diseases since 1992, after seeing the devastating effects that these diseases can have on patients. Dr. Fry’s clinical practice, as well as his interest in searching for unrecognized causative agents of autoimmune and chronic illnesses have driven his commitment to basic science research. Dr. Fry is a member of I.L.A.D.S., the American Society of Microbiology, the A.S.M., the Arizona Biotechnology Consortium, and the I.S.N.V.D.Lab Notes
Nothing posted yet.
Additional Information
Inflammation, parasites, and cancer have long been interconnected. We have included some images of interest showing some of the known human blood-dwelling parasites, Schistosoma induced cancer, and prostate cancer pathology. For more research supporting links between cancer and infections we suggest these publications:Chronic Bacterial Infections and Cancer Risk Colorectal Cancer and Schistosoma Schistosoma Prostate Case Report #1 Schistosoma Prostate Case Report #2 Parasitic Infection and Cancer
Babesia microti on thin blood smear examination (SWCCD, 2013)
Granuloma surrounding a Schistosoma egg (Flickr user Yale Rosen)

Trypanosoma species visible via thin blood smear examination (SWCCD, 2014)
Metastatic prostate adenocarcinoma (Flickr user Yale Rosen)

Plasmodium species visible via thin blood smear (SWCCD, 2014)
Project Backers
- 2Backers
- 1%Funded
- $20Total Donations
- $10.00Average Donation
